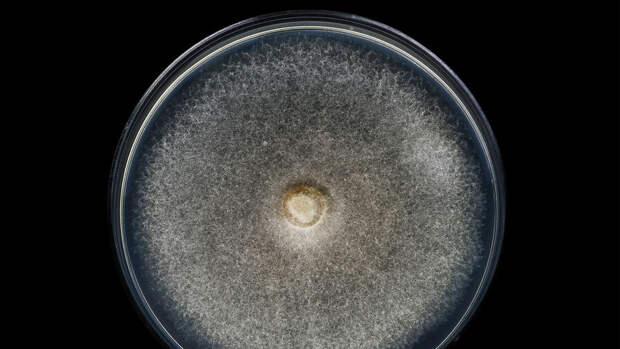

В России подвели итоги конкурса "Снимай науку!", посвященный научным фотографиям - от снимков Млечного пути и северного сияния до фото пластикового пакета в поляризованном свете. Работы принимались в восьми номинациях, призванных показать красоту природы и космоса, результаты научных экспериментов и самих ученых за работой.
Конкурс, организованный телеканалом "Наука" совместно с российским отделением интернет-энциклопедии Wikipedia "Викимедиа РУ", проводится с 2017 года. В 2022 году на него поступило 2500 работ.
С работами победителей - например, снимком ученого в процессе считывания данных с автономной метеостанции на Шпицбергене или фото витамина D в стократном увеличении - можно ознакомиться в галерее "Газеты.Ru".

Свежие комментарии